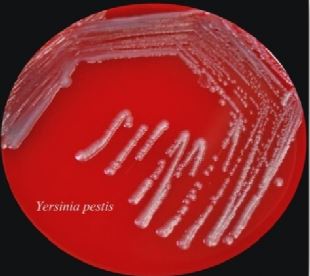
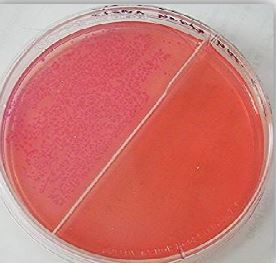
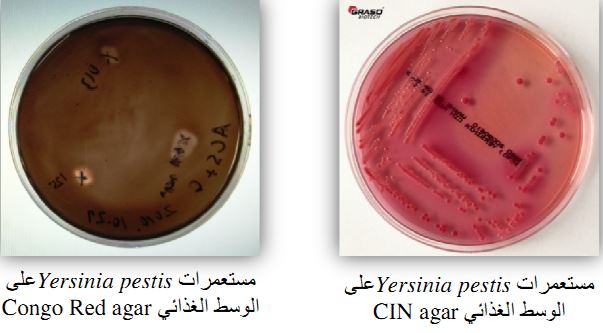

النبات

مواضيع عامة في علم النبات

الجذور - السيقان - الأوراق

النباتات الوعائية واللاوعائية

البذور (مغطاة البذور - عاريات البذور)

الطحالب

النباتات الطبية


الحيوان

مواضيع عامة في علم الحيوان

علم التشريح

التنوع الإحيائي

البايلوجيا الخلوية


الأحياء المجهرية

البكتيريا

الفطريات

الطفيليات

الفايروسات


علم الأمراض

الاورام

الامراض الوراثية

الامراض المناعية

الامراض المدارية

اضطرابات الدورة الدموية

مواضيع عامة في علم الامراض

الحشرات


التقانة الإحيائية

مواضيع عامة في التقانة الإحيائية


التقنية الحيوية المكروبية

التقنية الحيوية والميكروبات

الفعاليات الحيوية

وراثة الاحياء المجهرية

تصنيف الاحياء المجهرية

الاحياء المجهرية في الطبيعة

أيض الاجهاد

التقنية الحيوية والبيئة

التقنية الحيوية والطب

التقنية الحيوية والزراعة

التقنية الحيوية والصناعة

التقنية الحيوية والطاقة

البحار والطحالب الصغيرة

عزل البروتين

هندسة الجينات


التقنية الحياتية النانوية

مفاهيم التقنية الحيوية النانوية

التراكيب النانوية والمجاهر المستخدمة في رؤيتها

تصنيع وتخليق المواد النانوية

تطبيقات التقنية النانوية والحيوية النانوية

الرقائق والمتحسسات الحيوية

المصفوفات المجهرية وحاسوب الدنا

اللقاحات

البيئة والتلوث


علم الأجنة

اعضاء التكاثر وتشكل الاعراس

الاخصاب

التشطر

العصيبة وتشكل الجسيدات

تشكل اللواحق الجنينية

تكون المعيدة وظهور الطبقات الجنينية

مقدمة لعلم الاجنة


الأحياء الجزيئي

مواضيع عامة في الاحياء الجزيئي


علم وظائف الأعضاء


الغدد

مواضيع عامة في الغدد

الغدد الصم و هرموناتها

الجسم تحت السريري

الغدة النخامية

الغدة الكظرية

الغدة التناسلية

الغدة الدرقية والجار الدرقية

الغدة البنكرياسية

الغدة الصنوبرية

مواضيع عامة في علم وظائف الاعضاء

الخلية الحيوانية

الجهاز العصبي

أعضاء الحس

الجهاز العضلي

السوائل الجسمية

الجهاز الدوري والليمف

الجهاز التنفسي

الجهاز الهضمي

الجهاز البولي


المضادات الميكروبية

مواضيع عامة في المضادات الميكروبية

مضادات البكتيريا

مضادات الفطريات

مضادات الطفيليات

مضادات الفايروسات

علم الخلية

الوراثة

الأحياء العامة

المناعة

التحليلات المرضية

الكيمياء الحيوية

مواضيع متنوعة أخرى

الانزيمات
الجنس Yersinia pestis
المؤلف:
عبد الرزاق سليمان التومي ، محمد محمد الامام ، عبد الباسط رمضان
المصدر:
اساسيات التشخيص البكتريولوجي المعملي والسريري
الجزء والصفحة:
24-7-2016
5187
Yersinia pestis
خلايا هذا النوع البكتيري صغيرة وسالبة لصبغة جرام وغير متحركة كما أن شكلها عصو ــ كروي ، ويبلغ حجمها حوالي 1.5 X 0.7 ميكرومتر.
ويكون هذا النوع البكتيري حافظة وعند صبغ الخلايا بأزرق الميثيلين methylene blue او صبغة Giemsa أو صبغة Wayson's rapid stain نلاحظ احتفاظ أقطاب الخلية بالصبغة bipolar staning (تبدو الخلية البكتيرية كشكل دبوس الآمان) مع ضرورة مراعات تثبيت اللطاخة البكتيرية باستعمال الكحول الميثانولي لمدة 5 دقائق بدلاً من التسخين.

خلايا النوع البكتيري Yersinia pestis
الامراضية :
يسبب هذا النوع البكتيري مرض الطاعون plague او ما كان يعرف بالموت الأسود black death أو الطاعون الدبلي bubonic plague، وهو مرض ينتقل من الحيوان إلى الإنسان zoonotic disease ، حيث ينتقل من الفئران والقوارض الاخرى من خلال حشرة flea وهي (Xenopsylla cheopis و X. brasiliensis).

الحشرة flea الناقلة للكائن الممرض
وتحدث الإصابة إما من خلال استنشاق الكائن الممرض المحمول في الرذاذ أو من خلال ملامسة القوارض أو الحيوانات الأليفة التي تستعملها الحشرة كعائل لها أو من خلال الحشرة الناقلة للمرض مباشرة وهناك ثلاثة أشكال لمرض الطاعون وهي:
ــ الطاعون الدبلي bubonic plague :

وهو أكثر الأشكال انتشاراً ويتصف بحمى شديدة والتهاب للقعد اليمفاوية acute lumphadenitis مع ظهور انتفاخ مدمي مصحوب بألم ويسمى buboes وغالباً ما يتكون في منطقة أصل الفخذ groin agea ، كما أنه في الغالب ظهور هذا الانتفاخ في منطقة الرقبة أو الإبط وهذا يعتمد على مكان لسعة الحشرة ويصاحب ذلك زيادة عدد كريات الدم البيضاء وبالأخص العدلات neutrophilia .
ــ الطاعون الرئوي pneumonic plague :
وهو يحدث نتيجة الإصابة من خلال استنشاق الكائن الممرض او كنتيجة لانتشار الكائن الممرض من خلال الدم ليصل إلى الرئتين ، وهو يسبب التهاب الشعب الرئوية الحاد والمدمي haemorrhagic severe bronchopneumonia وهذا المرض مميت ما لم يتم علاج المريض بأسرع ما يمكن وفي المراحل الاولى من المرض كما أنه معدي بشكل كبير ومن الممكن انتشاره بسرعة خاصة في المناطق الفقيرة والمزدحمة . يحتوي بصاق الشخص المصاب على أعداد كبيرة من الكائن الممرض وفي الغالب يحتوي على دم.

الطاعون الرئوي pneumonic plague
ــ الطاعون المجرثم للدم septicaemic plague : وهو من اخطر الأشكال حيث تتواجد أعداد كبيرة من النوع البكتيري Y. pestit في الدم ويمكن الكشف عن البكتيريا الممرضة في عينة الدم الطرفية مع عدم تكون buboes في أغلب الحالات المصابة مع ظهور طفح جلدي مدمي haemorrhagic rash وهو مميت بصورة سريعة.

معرفة التاريخ المرضي للمريض يساعد في التشخيص الافتراضي المبكر لمرض الطاعون ويتم التأكد بوجود الخلية البكتيرية المصبوغة الأقطاب في رائح الدبل hubo aspirates ويمكن استعمال المضاد الحيوي streptomycin أو المضاد الحيوي tetracycline أو المضاد الحيوي chloramphenicol لعلاج المراحل الاولى من الإصابة مع الأخذ في الاعتبار أن بعض السلالات أظهرت مقاومة للمضاد الحيوي streptomycin والمضاد الحيوي tetracycline .
التشخيص المعملي :
يدب مراعات كافة سبل الآمان الحيوي حيث أن النوع البكتيري Y. pestis معدي بصورة كبيرة وهو بندرج ضمن المجموعة الخطرة الثالثة (Hazard Risk Group 3) مع مراعات مناولة العينات بحذر شديد لمنع انتشار الرذاذ.
من العينات التي يتم زراعتها راشح الدبل bubos aspirates والبصاق وعينة الدم وفي الحالات التي يشك أنها للإصابة بمرض الطاعون يتم أخذ عينة دم وتوضع في EDTA لفحص مدى وجود الخلايا البكتيرية المصبوغة من الأقطاب مع مراعات أخذ العينات قبل البدء في العلاج بالمضادات الحيوية وإذا استلزم الأمر نقل عينات راشح الدبل أو الدم إلى معمل خارجي فيجب أن يتم ذلك في حافظة محكمة الغلق مع وجود الثلج ولا يتم إرسال عينة البصاق على ان ترفق معها نتيجة التحليل المبدئية والتاريخ المرضي للشخص المصاب. ولتنمية هذا النوع البكتيري يتم حضانته في درجة حرارة 37-14 درجة مئوية وتعتبر درجة الحرارة 27 درجة مئوية الدرجة المثلى للنمو ولذلك يفضل ترك العينات في درجة حرارة الغرفة.

ــ الوسط الغذائي Blood agar : تنمو المستعمرات البكتيرية بشكل جيد على هذا الوسط الغذائي مكونة مستعمرات لماعة صغيرة الحجم ويكون لونها أبيض إلى رمادي ويميل للاصفرار وشكل المستعمرات يكون معتم ومنتفخة وهي غير محللة لكريات الدم الحمراء وذلك بعد تحضينها لمدة 48-24 ساعة في درجة حرارة الغرفة.
مستعمرات Yersinia pestis على الوسط الغذائي Blood agar
ــ الوسط الغذائي MacConkey : المستعمرات النامية تكون شفافة وصغيرة جداً وبلون وردي وذلك بعد تحضينها لمدة 48-24 ساعة وهي غير قادرة على تخمير سكر اللاكتوز إلا أنها تظهر كأنها قادرة على تخمير هذا السكر وذلك نظراً لقدرتها على الاستفادة من الصبغة الحمراء التي تستعمل ككاشف في هذا الوسط الغذائي.
الجزء العلوي : مستعمرات Yersinia على الوسط الغذائي MacConkey agar
ــ الوسط الغذائي CIN agar (الذي يتكون من المضاد الحيوي cefsulodin و Irganan والمضاد الحيوي novobiocin) والوسط الغذائي congo red agar : وهي أوساط غذائية انتقائية لهذا النوع البكتيري ، وإذا ما كان الغرض من استعمالهم لاختبار (Farction 1) capsulae antigen فلابد من تحضين العينة في درجة حرارة 37 درجة مئوية لتهيئة الظروف لتكوين مستضد الحافظة.
الاختبارات المعملية :
ــ اختبار الكشف على انزيم catalase : موجب.
ــ اختبار الكشف على انزيم oxidase : سالب . وهو يفيد في التفريق بين النوع البكتيري Y. pestis والنوع البكتيري Y. pseudomallei.
هناك اختبار سريع للكشف على الاصابة بالطاعون الدبالى والطاعون الرئوي في خلال 15 دقيقة وذلك بالكشف على مستضد النوع البكتيري Y. pestis في عينة راشح الدبل أو البصاق وهي تسمى Dipstick test وهي طريقة فعالة جداً.
الاكثر قراءة في البكتيريا
اخر الاخبار
اخبار العتبة العباسية المقدسة
الآخبار الصحية

قسم الشؤون الفكرية يصدر كتاباً يوثق تاريخ السدانة في العتبة العباسية المقدسة
"المهمة".. إصدار قصصي يوثّق القصص الفائزة في مسابقة فتوى الدفاع المقدسة للقصة القصيرة
(نوافذ).. إصدار أدبي يوثق القصص الفائزة في مسابقة الإمام العسكري (عليه السلام)